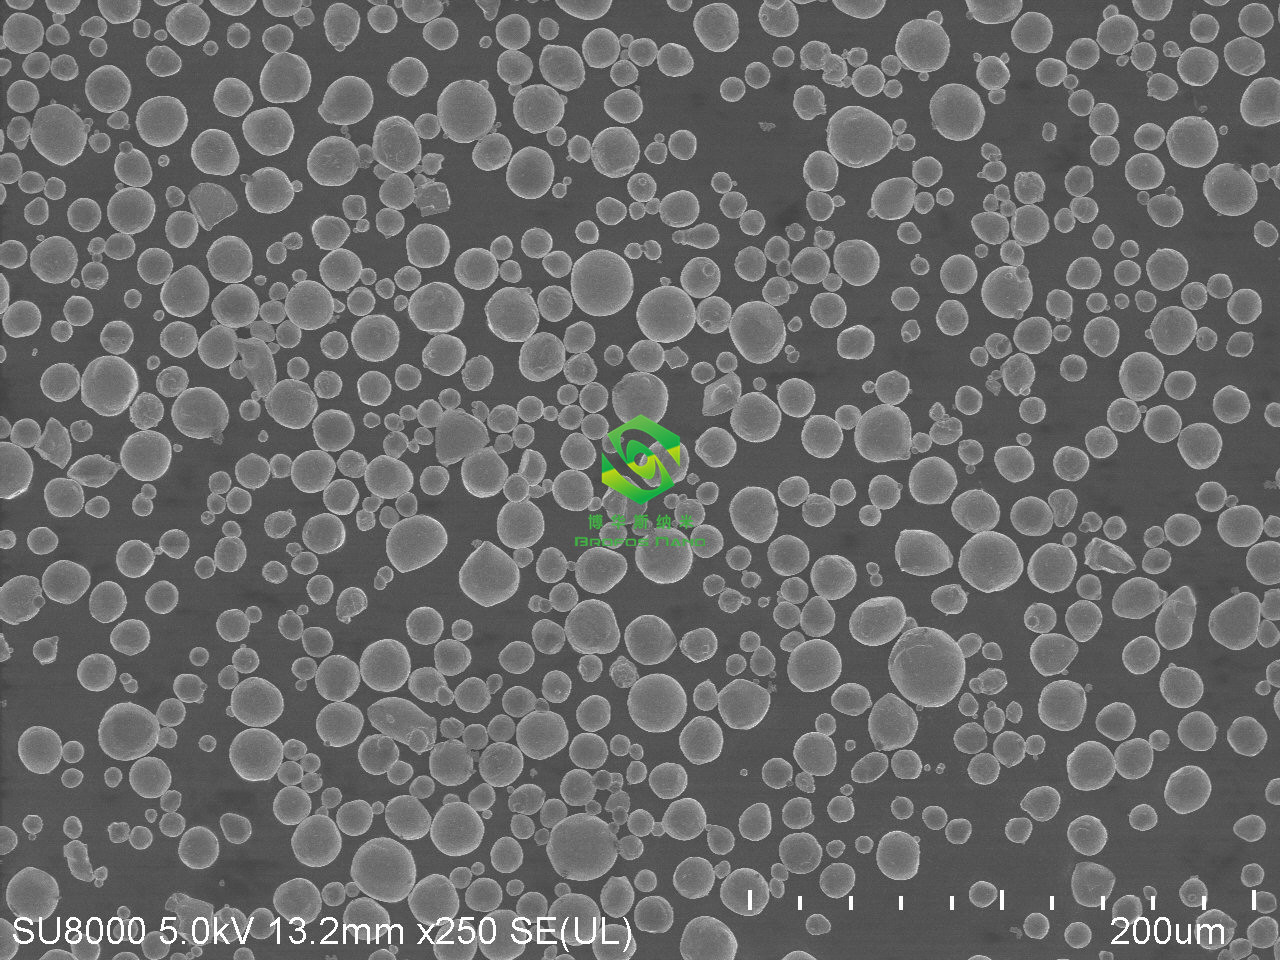

全部9个规格
| 颜色分类 | 售价 | 原价 | 库存 | 重量 | 体积 | 编码 | 条码 | 购买数量 | 操作 |
|---|---|---|---|---|---|---|---|---|---|
| 铋粉-20nm-100g(实验专用) | ¥ 登录可见 | ¥ 登录可见 | 9999 件 | 614186213446 |
|
||||
| 铋粉-50nm-100g(实验专用) | ¥ 登录可见 | ¥ 登录可见 | 9999 件 | 614186213446 |
|
||||
| 铋粉-80nm-100g(实验专用) | ¥ 登录可见 | ¥ 登录可见 | 9999 件 | 614186213446 |
|
||||
| 铋粉-100nm-100g(实验专用) | ¥ 登录可见 | ¥ 登录可见 | 9999 件 | 614186213446 |
|
||||
| 铋粉-1um-100g(实验专用) | ¥ 登录可见 | ¥ 登录可见 | 9999 件 | 614186213446 |
|
||||
| 铋粉-10um-100g(实验专用) | ¥ 登录可见 | ¥ 登录可见 | 9999 件 | 614186213446 |
|
||||
| 铋粉-500目-100g(实验专用) | ¥ 登录可见 | ¥ 登录可见 | 9999 件 | 614186213446 |
|
||||
| 铋粉-300目-100g(实验专用) | ¥ 登录可见 | ¥ 登录可见 | 9999 件 | 614186213446 |
|
||||
| 如需其他粒径及用量 欢迎咨询 | ¥ 登录可见 | ¥ 登录可见 | 9999 件 | 614186213446 |
|

没有相关规格
看了又看